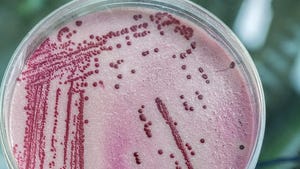

-
 Elevated levels of Legionaella detected in bathrooms, water fountains at Detroit's McNamara Federal BuildingDecember 12, 2023
Elevated levels of Legionaella detected in bathrooms, water fountains at Detroit's McNamara Federal BuildingDecember 12, 2023 -
 Stellantis to conduct water testing after Legionnaires outbreak strikes Warren Truck Assembly PlantAugust 9, 2023
Stellantis to conduct water testing after Legionnaires outbreak strikes Warren Truck Assembly PlantAugust 9, 2023 -
 Cases of Legionnaires’ disease spike in 25 Michigan countiesJuly 20, 2021
Cases of Legionnaires’ disease spike in 25 Michigan countiesJuly 20, 2021 -
 Officials Investigate Link Between Legionnaires' Disease And Macomb County HospitalOctober 10, 2019
Officials Investigate Link Between Legionnaires' Disease And Macomb County HospitalOctober 10, 2019 -
 Michigan Launches Statewide Investigation After Increase In Legionellosis CasesJuly 6, 2019
Michigan Launches Statewide Investigation After Increase In Legionellosis CasesJuly 6, 2019 -
 Michigan Orders Flint Hospital To Reduce Legionnaires' RisksJune 13, 2019
Michigan Orders Flint Hospital To Reduce Legionnaires' RisksJune 13, 2019 -
Officials Investigate Another Case Of Legionnaires' Disease Linked To McLaren Flint HospitalMay 11, 2019
Officials Investigate Another Case Of Legionnaires' Disease Linked To McLaren Flint HospitalMay 11, 2019